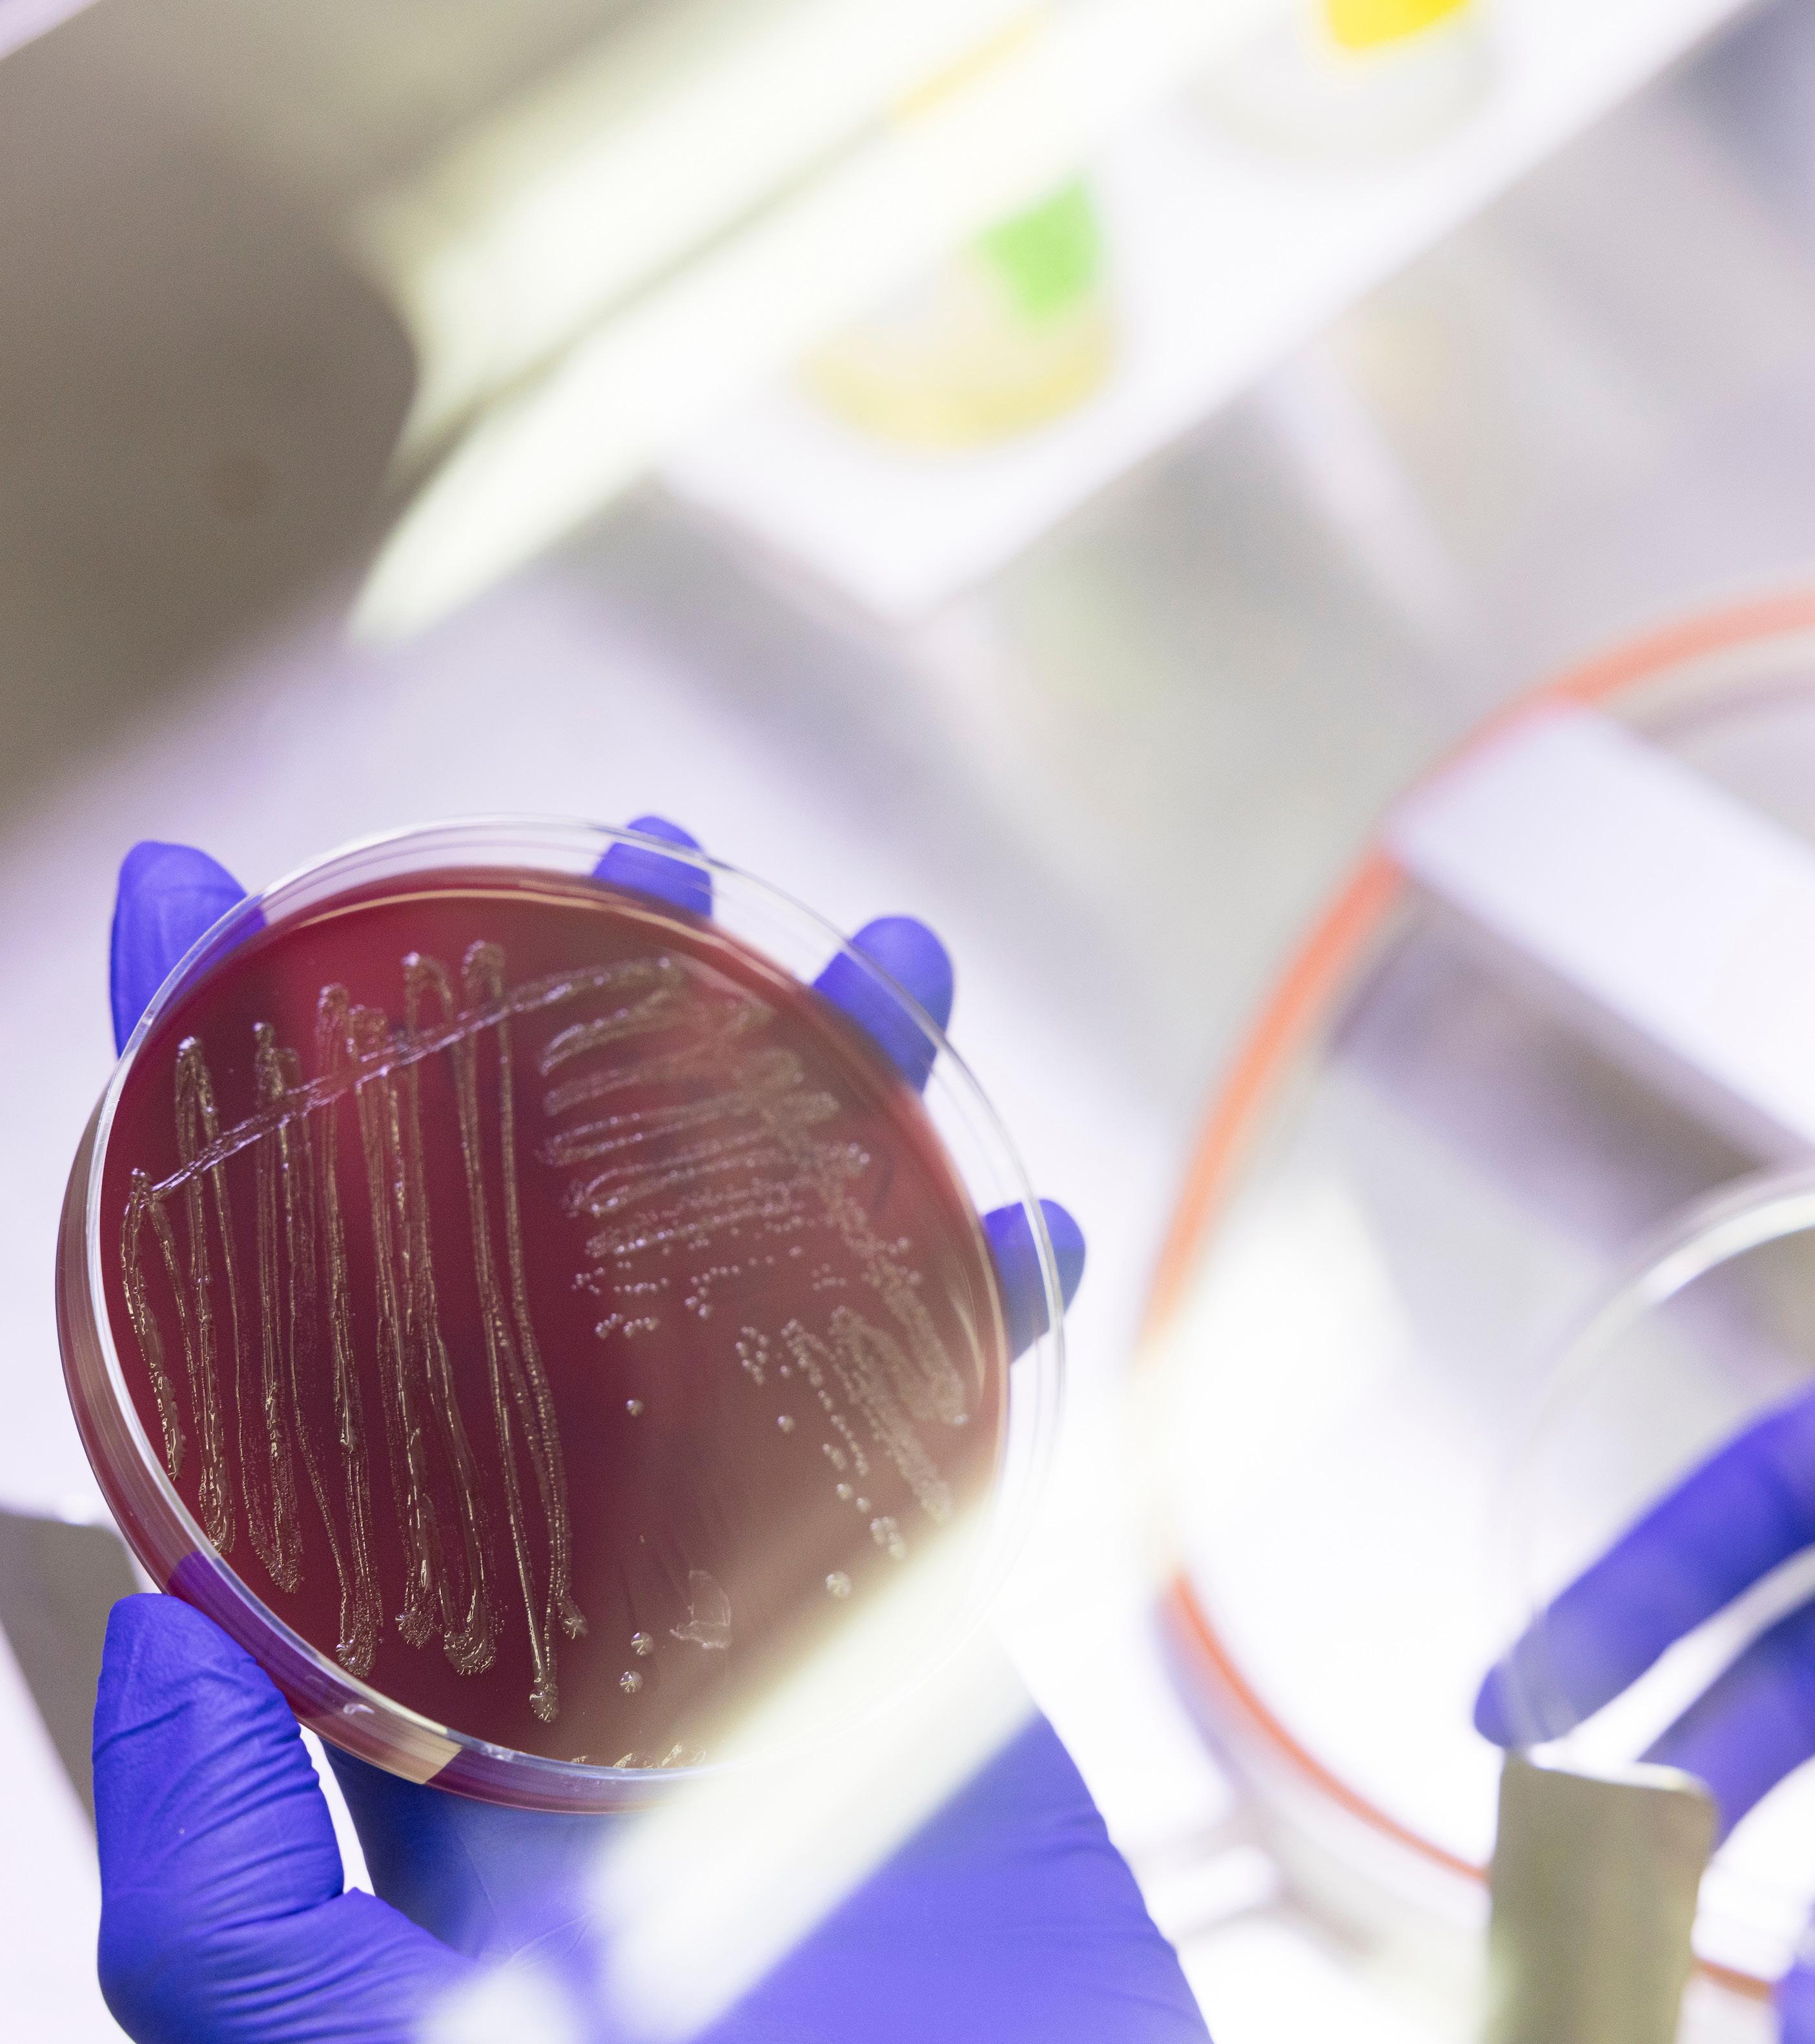

APRIL 15, 2026
Penn Dental Medicine 10:00am – 6:00pm
![]()

APRIL 15, 2026
Penn Dental Medicine 10:00am – 6:00pm
It is our great pleasure to welcome alumni, faculty, staff, students and friends to Penn Dental Medicine Research Day 2026.
We invite you to join us in celebrating as faculty, students, and research staff once again come together to showcase the breadth and strength of PDM’s research in a single venue. We look forward to a day of exchange and collaboration across disciplines that highlights the quality, depth, and diversity of the School’s research.
We warmly welcome this year’s keynote speakers. Jonathan Epstein, MD, Dean of the Raymond and Ruth Perelman School of Medicine and Executive Vice President of the University of Pennsylvania for the Health System, will deliver the Joseph L. Rabinowitz Memorial Lecture, “Treating Fibrosis with mRNA and CAR T Cells.” Laurie McCauley, DDS, MS, PhD, Provost and Executive Vice President for Academic Affairs at the University of Michigan, will present the PDM Research Day Keynote Lecture, “A Journey in Hormonal Actions, Immunology, Bone Biology and Discovery Science.” We are honored to have you with us for this important day.
Another highlight of the day is the presentation of research awards recognizing excellence and innovation across our community. Among these is the Joseph and Josephine Rabinowitz Award for Excellence in Research, established in 1992 by the late Dr. Joseph Rabinowitz, a longtime member of the School’s Biochemistry faculty, and his wife, Josephine, to support independent and collaborative faculty research. Today, this tradition has grown to include a broader portfolio of awards that celebrate outstanding achievement and encourage interdisciplinary scholarship across Penn Dental Medicine. Research Day will also recognize student and trainee accomplishments through a series of competitive awards and travel opportunities that support continued scholarly development. These include the AADOCR Student Research Day Award and the Student Competition for Advancing Dental Research and its Application (SCADA), as well as Penn Dental Medicine’s AADOCR Travel Awards, the Gail Schupak Travel Award, the Oral Cancer Award and the Vernon Brightman Award. Together, these programs provide critical support for students and junior investigators to present their work at national meetings, foster professional growth, and contribute to the future of dental research and discovery.
Penn Dental Medicine continues to build as a leader in the generation of new knowledge and in the cultivation of the next generation of oral health researchers. We hope the day will spark new collaborations, fresh insights, and continued innovation. Enjoy the day.
Dr. Dana T. Graves Chair
Dr. Esra Sahingur Co-chair
Dr. Joseph Fiorellini
Dr. Michael Glick
Dr. George Hajishengallis
Dr. Monica Chenshuang Li
Dr. Rob Ricciardi
Pamela Rice

Mark S. Wolff, D.D.S, PhD
Dana Graves, DDS, DMSc
Morton Amsterdam Dean Vice Dean for Scholarship and Research

9:55 AM OPENING REMARKS
Arthur E. Corby Auditorium
Dana T. Graves, DDS, DMSc
10:00 AM PENN DENTAL MEDICINE FACULTY PRESENTATIONS
Arthur E. Corby Auditorium
MODERATOR: Cagla Akay-Espinoza, MD
“Senescence, Inflammaging and Microbiome Axis in Periodontal Aging”
Esra Sahingur, DDS, MS, PhD
Associate Dean of Graduate Studies & Student Research Associate Professor, Department of Periodontics
MODERATOR: Hyeran Helen Jeon, DDS, MSD, DScD
“Unraveling Clinical and Molecular Pathways of Periodontitis Progression”
Flavia Teles, DDS, MS, DMSc
Professor, Department of Basic & Translational Sciences
MODERATOR: Yijing Su, PhD
“The Healing Blueprint: Enhanced Therapeutic Potentials of GMSCs”
Anh D. Le, DDS, PhD
Chair and Norman Vine Endowed Professor of Oral Rehabilitation, Department of Oral & Maxillofacial Surgery/Pharmacology
11:00 AM THE JOSEPH L. RABINOWITZ MEMORIAL LECTURE
Arthur E. Corby Auditorium
MODERATOR: Henry Daniell, PhD
“Treating Fibrosis with mRNA and CAR T cells”
Jonathan Epstein, MD
Dean of the Raymond and Ruth Perelman School of Medicine and Executive Vice President of the University of Pennsylvania for the Health System
12:00 PM LUNCH
Fonseca Gardens
12:45 PM POSTER PRESENTATIONS AND COMPETITIONS
Schattner Lobby, Lerner Pavilion, and Schattner Patient Waiting
2:45 PM TRANSITION BREAK
3:00 PM PDM RESEARCH DAY KEYNOTE LECTURE
Arthur E. Corby Auditorium
MODERATOR: Alonso Carrasco Labra, DDS, MSc, PhD
“A Journey in Hormonal Actions, Immunology, Bone Biology and Discovery Science”
Laurie McCauley, DDS, MS, PhD
Provost and Executive Vice President for Academic Affairs, University of Michigan
4:15 PM RECEPTION, RECOGNITION AND AWARDS
Fonseca Gardens
Esra Sahingur, DDS, MS, PhD


Provost and Executive Vice President for Academic Affairs
University of Michigan
Dr. Laurie McCauley serves as provost and executive vice president for academic affairs at the University of Michigan. Her leadership priorities have included student success, support for those with disabilities, and co-leading U-M’s Campus Planning and Strategic Visioning processes.
Dr. McCauley is a member of the National Academy of Medicine and a fellow of the American Association for the Advancement of Science. An NIH-supported researcher for over 25 years, her work focuses on bone biology and prostate cancer skeletal metastasis, contributing to regenerative medicine and treatments for bone loss.
Dr. McCauley is the former dean of the U-M School of Dentistry and the William K. and Mary Anne Najjar Professor of Periodontics as well as a professor of pathology in the Medical School.

Dean of the Raymond and Ruth Perelman School of Medicine and Executive Vice President of the University of Pennsylvania for the Health System
Jonathan A. Epstein, MD, serves as Dean of the Raymond and Ruth Perelman School of Medicine and Executive Vice President of the University of Pennsylvania for the Health System, together comprising Penn Medicine, an $11.9 billion enterprise dedicated to medical education, biomedical research, and patient care.
Founded in 1765, the Perelman School of Medicine is the nation’s first medical school and now includes more than 3,100 faculty and over 4,500 learners, with more than $1 billion in annual sponsored research. The University of Pennsylvania Health System features nationally ranked hospitals and a broad clinical network across primary and specialty care.
Dr. Epstein, a graduate of Harvard College and Harvard Medical School, completed his training at Brigham and Women’s Hospital and joined Penn in 1996. Over nearly three decades, he has held key leadership roles, including Executive Vice Dean and Chief Scientific Officer, helping to shape Penn Medicine into a global leader in research and innovation.
He holds the Robert G. Dunlop Professorship and previously chaired the Department of Cell and Developmental Biology, served as Scientific Director of the Penn Cardiovascular Institute, and co-founded the Penn Institute for Regenerative Medicine.
A leading physician-scientist, his research focuses on congenital heart disease, heart failure, stem cell biology, and epigenetics, with recent advances in mRNA-based therapies. His honors include the Sir William Osler Young Investigator Award and election to the American Academy of Arts and Sciences and the National Academy of Medicine.



The Joseph and Josephine Rabinowitz Award for Excellence in Research was designed to help Penn Dental Medicine faculty undertake pilot projects that will enable them to successfully apply for extramural sources of funding. Designed through the lens of a researcher, this ongoing grant evaluates research proposals for their scholarly merit, creativity and innovation; the significance of the research in advancing scientific knowledge; the prospects for future extramural funding; the availability of alternate funding sources; and in the case of junior faculty, evidence that the applicant will be working as an independent investigator and forwarding of the School’s research objectives. It was under development as early as 1994 with the first award presented in 2002.
This award was endowed through the generosity of the late Dr. Joseph “Jose” Rabinowitz, an active member of the School’s biochemistry faculty for 29 years, and his wife, the late Dr. Josephine “Josy,” a fellow Penn alum. Josy’s PhD was in the field of education. Her strong endorsement of education and research provided a hand in the development of this grant. Jose was known for his research in lipid and steroid biochemistry, and made the seminal discovery that HMG CoA was a key intermediate in cholesterol biosynthesis. His research helped lead to the development of the important class of cholesterollowering drugs known as statins.
The Rabinowitz family continues to support the values and priorities of this award and congratulates its newest recipients.
Lauren C. Yap DMD, MPH
Clinical Assistant Professor, Assistant Program Director for Postdoctoral Pediatric Dentistry Program Department of Preventive and Restorative Sciences, Division of Pediatric Dentistry
Oral Microbiome Changes in Children Placed on a Ketogenic Diet
The ketogenic diet is comprised of a high-fat, low-carbohydrate regimen used for weight management and therapeutic purposes in conditions such as epilepsy, Alzheimer’s disease, and type 2 diabetes. The objective of the study is to determine the effect of the ketogenic diet on the composition and functional potential of the dental plaque microbiome in children. By identifying microbial shifts and changes in metabolic pathways associated with a ketogenic diet, critical insight can be provided into the potential oral health implications of ketogenic dietary therapy. The link between carbohydrate consumption and the pathogenesis of dental caries is well-documented, however the impact of the ketogenic diet on oral ecology remains largely unexplored. This pilot study seeks to characterize changes in dental plaque microbial composition following the initiation of this diet regimen. By investigating these shifts, the project intends to unveil how dietary-induced ketosis modulates oral health, potentially informing novel diagnostic and therapeutic strategies for the pediatric populations.
Wenjing Yu, DDS, PhD, DScD,
Assistant Professor, Associate Director of Predoctoral Orthodontics Program
Department of Orthodontics
The role of Gli1+ Chondroprogenitor Cells in Degenerative Temporomandibular joint (TMJ) Diseases
Temporomandibular joint disease (TMD) is a degenerative musculoskeletal disorder that causes morphological and functional abnormalities. Degenerative Joint Disorders (DJD) of the temporomandibular joint (TMJ) represent a challenging and multifaceted group of conditions that severely impact the joint’s function and patient’s quality of life. Histologically, the DJD of the TMJ is caused by damage or breakdown of the joint cartilage between bones. Despite its prevalence and impact, there are no specific therapeutics that target its root cause. We hypothesize that a group of chondroprogenitor cells (CPC) plays a critical role in maintaining bone homeostasis and preventing the progression of degenerative joint disease in the TMJ. This proposed study aims to identify novel endogenous stem/progenitor cell sources for cartilage tissue regeneration, with a focus on Gli1+ CPCs, derived from the mandibular condyle, that exhibit cartilage regenerative capacity.


Esra Sahingur, DDS, MS, PhD
Associate
Dean
of Graduate Studies & Student Research
Associate Professor, Department of
Periodontics
This lecture explores the interplay between inflammation, cellular senescence, and the microbiome in periodontal aging. It highlights how chronic inflammation and microbial dysbiosis drive senescence, leading to a cycle of “inflammaging” that contributes to periodontal disease progression and systemic health connections. The session also introduces emerging therapeutic strategies, including senotherapeutics, targeting senescence and inflammation to improve periodontal outcomes
Educational Objectives
• Describe the role of cellular senescence and SASP in the pathogenesis of periodontal disease.
• Explain the interactions between inflammation, microbial dysbiosis, and aging in periodontal tissues.
• Discuss emerging senotherapeutic approaches and their potential impact on periodontal and systemic health.
Flavia Teles, DDS, MS, DMSc
Professor, Department of Basic & Translational Sciences
Periodontitis is a complex, multifactorial inflammatory disease that results in the destruction of the tooth-supporting tissues and remains one of the most prevalent chronic conditions worldwide. Despite decades of research, the mechanisms that determine why some individuals experience rapid disease progression while others remain stable remain unclear. This lecture explores how integrative clinical and molecular approaches are reshaping our understanding of periodontitis progression, highlighting novel biomarkers, microbial signatures, and host–microbe interactions that define disease trajectories. Through a synthesis of clinical evidence and mechanistic insight, this lecture invites participants to reconsider periodontitis not as a static disease entity but as a dynamic process shaped by continuous host–microbial interactions. Understanding these pathways holds the promise of transforming diagnosis, monitoring, and treatment.
Educational Objectives
• Describe how integrative clinical and molecular approaches—such as longitudinal cohort studies and multi-omics analyses— enhance understanding of the mechanisms driving periodontitis progression and patient heterogeneity.
• Explain the key biological pathways involved in periodontal tissue destruction and resolution failure, including the roles of host inflammatory mediators, complement activation, cellular senescence, and microbial dysbiosis.
• Evaluate emerging translational tools and molecular biomarkers that support early detection, personalized risk assessment, and precision-based interventions in periodontal care.
Anh D. Le, DDS, PhD
Chair and Norman Vine Endowed Professor of Oral Rehabilitation Department of Oral & Maxillofacial Surgery/Pharmacology
Orofacial mesenchymal stem cells, easily accessible and enriched in neural crest properties, rapid proliferation, and multipotent differentiation, are excellent candidate cell sources for potential application in tissue engineering and regenerative therapy. Our research group has extensively characterized mesenchymal stem cells derived from human gingival tissues (GMSCs) as unique stem cells for tissue engineering, soft and hard tissue regeneration, and immunomodulatory functions. Patient derived GMSC could be directly induced into multipotent NPCs (iNPCs) under minimally manipulated culture conditions without the introduction of exogenous genes. These induced GMSCs are also capable of releasing extracellular vesicles (EVs), including exosomes, with potent biological functions and therapeutic effects in several preclinical animal models, providing a safe cell-free therapeutic approach for tissue regeneration.
Educational Objectives
• Orofacial MSCs have enriched neural crest properties
• MSCs derived from gingival tissues (GMSCs) are capable of multipotent differentiation
• MSCs have immunomodulatory functions

*Junior Investigators include the following categories: Masters students, DScD students, Residents, Postdocs, Research Associates and Junior Faculty
HIV Disrupts CD4-Dependent Oral Microbiome–Inflammation Crosstalk in Pediatric Caries
Ibukun J. Abulude1, Aris Llada2, Allison Mann3, Sukhwinder Singh2, Esosa Osagie4, Paul Akhigbe4, Anil Kumar5, Ozoemene Obuekwe6, Vincent P. Richards7, Praise Okoh-Aihe5
Modupe O. Coker5,8,9
University of Pennsylvania School of Dental Medicine, 2Rutgers New Jersey Medical School, Department of Pathology, Immunology and Laboratory Medicine, 3University of Wyoming, Department of Anthropology, 4Institute of Human Virology Nigeria, International Research Centre for Excellence, 5University of Pennsylvania School of Dental Medicine, Center for Clinical and Translational Research, 6University of Benin Teaching Hospital, 7Clemson University, Department of Biological Sciences, 8University of Pennsylvania School of Dental Medicine, Department of Oral Medicine, 9University of Pennsylvania School of Dental Medicine, Department of Basic and Translational Sciences
RD-2
mTOR Activation in Adipo-Precursor Remodels Marrow Niche and Bone Homeostasis
Arwa Abumansour1, Xiaobin Huang1, Shilan Zhang2
Chider Chen3
University of Pennsylvania School of Dental Medicine, 2University of Pennsylvania School of Dental Medicine, Department of Basic and Translational Sciences, 3University of Pennsylvania School of Dental Medicine, Department of Oral & Maxillofacial Surgery / Pharmacology
Cross Kingdom Biofilm Analysis on Inlays and Onlays Construct of Piezoelectric Composite
Ahmed Alqalam1, Hyejoo Kim2, Pratik Nag2
Geelsu Hwang2,3,4
University of Pennsylvania School of Dental Medicine, 2University of Pennsylvania School of Dental Medicine, Department of Preventive and Restorative Sciences, 3University of Pennsylvania School of Dental Medicine, Center for Innovation & Precision Dentistry, 4University of Pennsylvania School of Dental Medicine, Center for Clinical and Translational Research
RD-4
In-Vitro Comparative Study of Fit Accuracy Between Conventional, 3D-Printed, and Hybrid Hollow Bulb Obturators Using Digital Superimposition and Heat-Map Analysis
Mohammad Alshemali1
Nupur Patel1,2,3, Brian M. Chang2,4,5,6, Francis Mante7, Yu-Chun Lin7, Harshiv Karia8, Sebastian Ollinger2
1University of Pennsylvania School of Dental Medicine, Department of Prosthodontics, 2University of Pennsylvania School of Dental Medicine, Department of Preventive and Restorative Sciences, 3University of Pennsylvania School of Dental Medicine, Advanced Education Program in Prosthodontics, 4University of Pennsylvania School of Dental Medicine, Department of Oral & Maxillofacial Surgery / Pharmacology, 5Hospital of University of Pennsylvania, Maxillofacial Prosthodontics, 6Hospital of University of Pennsylvania, The Penn Center for Innovative & Personalized Oral Rehabilitation, 7University of Pennsylvania School of Dental Medicine, 8University of Connecticut School of Dental Medicine
Designing Bispecific Antibodies Targeting Glycoproteins gB and gD of Herpes Simplex Virus
Doina Atansiu1, Wan Ting Saw1
Harvey M. Friedman2,3, Gary H. Cohen1
1University of Pennsylvania School of Dental Medicine, Department of Basic and Translational Sciences, 2University of Pennsylvania Perelman School of Medicine, Division of Infectious Diseases, 3Penn Institute for RNA Innovation
RD-6
Local Drug Delivery of 1,4 DPCA using PLGA Therapeutic Ligatures: A Novel Strategy for Periodontal Bone Regeneration.
Lina Baeesa1, Jiaxin Liu1, Azamat Aslanukov2
Ellen Heber-Katz2, George Hajishengallis1
1University of Pennsylvania School of Dental Medicine, Department of Basic and Translational Sciences, 2Lankenau Institute for Medical Research, Clinical Research
RD-7
Treatment Planning for Periodontally Compromised Teeth: To Treat and Maintain or to Extract and Pursue Implant Therapy
Mirza A. Baig
University of Pennsylvania School of Dental Medicine
RD-8
Matrix Mechanics Regulate TumorMyeloid Crosstalk in Oral Squamous Cell Carcinomas
Amanda S. Bluem1, Fathmeh Tavakoli Joorabi1,2, Yu-Chang J. Chen1,2
Kyle H. Vining2,3,4
1University of Pennsylvania School of Engineering and Applied Science, Department of Bioengineering, 2University of Pennsylvania School of Engineering and Applied Science, Department of Materials Science and Engineering, 3University of Pennsylvania School of Dental Medicine, Department of Preventive and Restorative Sciences, 4University of Pennsylvania School of Dental Medicine, Center for Innovation & Precision Dentistry
Antibody Responses to Key Epitopes in HSV-2 gC, gD and gE Fluctuate Over Time In Persons with Frequent Genital Recurrences
Tina M. Cairns1, Lauren M. Hook2, Doina Atansiu1, Wan Ting Saw1, Christine Johnston3, Anna Wald3, Harvey M. Friedman2,4
Gary H. Cohen1
1University of Pennsylvania School of Dental Medicine, Department of Basic and Translational Sciences, 2University of Pennsylvania Perelman School of Medicine, Division of Infectious Diseases, 3University of Washington, Department of Medicine, 4Penn Institute for RNA Innovation
Investigating the Mechano-Inflammatory Response of Dental Pulp Stem Cells Using 3D Artificial Extracellular Matrix
BingLing Chen1,2,3, Shuchen Zhang4, Jingyi Liu4,5,6, Hardikk Makkar4,6, Yu-Chang J. Chen5,7, Kyle H. Vining4,5,6,7
University of Pennsylvania School of Arts and Sciences, Department of Biology, 2Children’s Hospital of Philadelphia, Craniofacial Orthodontics, 3University of Pennsylvania School of Dental Medicine, 4University of Pennsylvania School of Dental Medicine, Department of Preventive and Restorative Sciences, 5University of Pennsylvania School of Engineering and Applied Science, Department of Bioengineering, 6University of Pennsylvania School of Dental Medicine, Center for Innovation & Precision Dentistry, 7University of Pennsylvania School of Engineering and Applied Science, Department of Materials Science and Engineering
Matrix Stress Relaxation Regulates the Functions of Stem Cell-Derived Dendritic Cells
Yu-Chang J. Chen1,2, Nghi M. Tran2, Shuchen Zhang3, Amanda S. Bluem2, Fathmeh Tavakoli Joorabi1,2, Kexin Zhang1, Hardikk Makkar3,4
Kyle H. Vining1,3,4
University of Pennsylvania School of Engineering and Applied Science, Department of Materials Science and Engineering, 2University of Pennsylvania School of Engineering and Applied Science, Department of Bioengineering, 3University of Pennsylvania School of Dental Medicine, Department of Preventive and Restorative Sciences, 4University of Pennsylvania School of Dental Medicine, Center for Innovation & Precision Dentistry
Transcriptomic Profiling of Host Immune Responses to Aggregatibacter actinomycetemcomitans Leukotoxin and Cytolethal Distending Toxin Using Bulk RNA Sequencing
Rebecca Choi1
Kathleen Boesze-Battaglia2, Anuradha Dhingra2, Bruce Shenker2, John Tobias3, Taewan Kim1
University of Pennsylvania School of Dental Medicine, Department of Periodontics, 2University of Pennsylvania School of Dental Medicine, Department of Basic and Translational Science, 3University of Pennsylvania Perelman School of Medicine, Department of Bioinformatics
Reliability of Full-Arch Tooth-Supported Digital Impression and Accuracy of Selective Rescanning of Finish Line Under Lock Area Feature
Selina Guo1
Nupur Patel1,2,3
1University of Pennsylvania School of Dental Medicine, Department of Prosthodontics, 2University of Pennsylvania School of Dental Medicine, Department of Preventive and Restorative Sciences, 3University of Pennsylvania School of Dental Medicine, Advanced Education Program in Prosthodontics
RD-14
Bacteria-Induced Cellular Redistrubiton of β-Catenin -E-Cadherin is Foxo1 Dependent and May Impact Barrier Function
Yu Jung Heo1, Minyoung A. Kwon2,3, Styliani Alimperti4,5
Dana T. Graves1,6,7
1University of Pennsylvania School of Dental Medicine, Department of Basic and Translational Sciences, 2University of Pennsylvania School of Dental Medicine, 3Children’s Hospital of Philadelphia, Craniofacial Orthodontics, 4University of Georgetown, Translational Medicine, 5Georgetown University, Biochemistry and Molecular & Cellular Biology Academic Department, 6University of Pennsylvania School of Dental Medicine, Department of Periodontics, 7University of Pennsylvania Perelman School of Medicine, The Penn Center for Musculoskeletal Disorders
Salivary Metagenomic Signatures Reveal Early Microbial Predictors of Periodontitis Progression and Stability
Cecilia C. Horchos1,2,3, Evelyn Santana3, Weiming Hu4,5, Kyle Bittinger5, Lynn Martin3,6
Flavia R.F. Teles2,3,6
1University of Pennsylvania School of Dental Medicine, Center for Clinical and Translational Research, 2University of Pennsylvania School of Dental Medicine, Department of Periodontics, 3University of Pennsylvania School of Dental Medicine, Department of Basic and Translational Sciences, 4Children’s Hospital of Philadelphia, Research Institute, 5Children’s Hospital of Philadelphia, Microbiome Center, 6University of Pennsylvania School of Dental Medicine, Center for Innovation & Precision Dentistry
Evaluation of an Injectable Zn–MOF Hydrogel for Antibacterial Treatment of Periodontal Infection
Jiayi Kang1, Keyu Chen2, Marco Tizzano3,4, Matteo Tizzano5, Flavia Teles4, Jiaxin Liu4, Jingyi Liu1,6,7, Rima Amin5
Kyle H. Vining6,7,8
1University of Pennsylvania School of Engineering and Applied Science, Department of Bioengineering, 2University of Michigan, Department of Materials Science and Engineering, 3University of Pennsylvania School of Dental Medicine, Center for Clinical and Translational Research, 4University of Pennsylvania School of Dental Medicine, Department of Basic and Translational Sciences, 5University of Pennsylvania School of Dental Medicine, 6University of Pennsylvania School of Dental Medicine, Department of Preventive and Restorative Sciences, 7University of Pennsylvania School of Dental Medicine, Center for Innovation & Precision Dentistry, 8University of Pennsylvania School of Engineering and Applied Science, Department of Materials Science and Engineering
Microstructural, Optical, and Mechanical Characterization of a New Dental Ceramic: Zpex4.m Yttria-Stabilized Zirconia
Min Joo Kim1, Zheng Li2,3
Yu Zhang2,3
1University of Pennsylvania School of Arts and Sciences, Department of Biology, 2University of Pennsylvania School of Dental Medicine, Department of Basic and Translational Sciences, 3University of Pennsylvania School of Dental Medicine, Department of Preventive and Restorative Sciences
RD-18
Inflammatory Profile After Third Molar Extraction is Associated with Supplemental Opioid Use
Miguel A. De Leon1, Stacey A. Secreto1,2, Gaurav Gupta3, Steven Wang1,4, Neeraj Panchal1, Brian P. Ford1, John T. Ford5, Elliot V. Hersh1, Tilo Grosser6
Katherine N. Theken1
1University of Pennsylvania School of Dental Medicine, Department of Oral & Maxillofacial Surgery / Pharmacology, 2University of Pennsylvania School of Dental Medicine, Center for Clinical and Translational Research, 3University of Pennsylvania School of Dental Medicine, 4University of Pennsylvania Perelman School of Medicine, Department of Oral and Maxillofacial Surgery, 5University of Pennsylvania Perelman School of Medicine, 6Bielefeld University
RD-19
DEL-1 is a Novel Endogenous Senolytic Protein that Inhibits SenescenceAssociated Bone Loss
Jong-Hyung Lim
University of Pennsylvania School of Dental Medicine, Department of Basic and Translational Sciences
RD-20
Oral Microbiome Changes in Children Placed on a Ketogenic Diet
Amy S. Lin1, Lauren Yap1,2, Yuan Liu3, Evlambia Hajishengallis1,2
University of Pennsylvania School of Dental Medicine, Department of Clinical Pediatric Dentistry, 2Children’s Hospital of Philadelphia, Department of Pediatrics, 3Maurice H. Kornberg School of Dentistry at Temple University, Department of Oral Health Sciences
RD-21
Sublingual Caruncle Taste Buds drive Taste Perception and Salivary Reflexes
Jiaxin Liu1, Ranhui Xi1
Marco Tizzano1,2
University of Pennsylvania School of Dental Medicine, Department of Basic and Translational Sciences, 2University of Pennsylvania School of Dental Medicine, Center for Clinical and Translational Research
RD-22
The ECM-Cytoskeletal-Nuclear Axis Regulates Gingival Immune Homeostasis Through Stiffness-Dependent Nuclear Compaction and DNA Methylation
Hardikk Makkar1,2, Vinayak Vinayak3, Kang I I. Ko4,5, Rebecca G. Wells6,7, Vivek B. Shenoy3,7
Kyle H. Vining1,2,3
University of Pennsylvania School of Dental Medicine, Department of Preventive and Restorative Sciences, 2University of Pennsylvania School of Dental Medicine, Center for Innovation & Precision Dentistry, 3University of Pennsylvania School of Engineering and Applied Science, Department of Materials Science and Engineering, 4University of Pennsylvania School of Dental Medicine, Center for Clinical and Translational Research, 5University of Pennsylvania School of Dental Medicine, Department of Periodontics, 6University of Pennsylvania Perelman School of Medicine, Department of Gastroenterology, 7Center for Engineering Mechanobiology
Potential Causes and Management of External Cervical Resorption in a Previously Endodontically Treated Tooth: A Case Report
Angélica Medina Montañez
Meeta Chawla
University of Pennsylvania School of Dental Medicine
Biomechanical Assessment of ImplantSupported Prostheses in Fibula Free Flap
Jaw-in-a-Day Reconstruction Using Finite Element Analysis
Dina Mesmar1,2, Won Joo3, Brian M. Chang1,4,5,6
Nupur Patel1,2,7, Brian P. Ford4,8,9
1University of Pennsylvania School of Dental Medicine, Department of Preventive and Restorative Sciences, 2University of Pennsylvania School of Dental Medicine, Advanced Education Program in Prosthodontics, 3Robert Morris University, School of Engineering and Science Engineering, 4University of Pennsylvania School of Dental Medicine, Department of Oral & Maxillofacial Surgery / Pharmacology, 5Hospital of University of Pennsylvania, Maxillofacial Prosthodontics, 6Hospital of University of Pennsylvania, The Penn Center for Innovative & Personalized Oral Rehabilitation, 7University of Pennsylvania School of Dental Medicine, Department of Prosthodontics, 8Philadelphia VA Medical Center, 9Children’s Hospital of Philadelphia, Division of Plastic and Reconstructive Surgery
RD-25
The Upside Down and Restorations: Stranger Biofilms on HydroxyapatiteBased Tooth Models
Pratik Nag1, Hyejoo Kim1
Geelsu Hwang1,2,3
1University of Pennsylvania School of Dental Medicine, Department of Preventive and Restorative Sciences, 2University of Pennsylvania School of Dental Medicine, Center for Innovation & Precision Dentistry, 3University of Pennsylvania School of Dental Medicine, Center for Clinical and Translational Research
RD-26
Pain as Pathology and Prognosticator: Management in Oral and Maxillofacial Surgery
Richard Ni1, Monica Shen2
Brian P. Ford1,3,4
1University of Pennsylvania School of Dental Medicine, Department of Oral & Maxillofacial Surgery / Pharmacology, 2University of Pennsylvania School of Dental Medicine, 3Philadelphia VA Medical Center, 4Children’s Hospital of Philadelphia, Division of Plastic and Reconstructive Surgery
RD-27
Identifying Early Biomarkers Linking Periodontal Inflammation and Alzheimer’s Disease
Madison Orr1, Evelyn Santana2, Flavia R.F. Teles2,3,4
1University of Pennsylvania School of Dental Medicine, 2University of Pennsylvania School of Dental Medicine, Department of Basic and Translational Sciences, 3University of Pennsylvania School of Dental Medicine, Department of Periodontics, 4University of Pennsylvania School of Dental Medicine, Center for Innovation & Precision Dentistry
RD-28
Single-cell Spatial Transcriptomics
Unveil Pathologic Signatures of Inflamed Peri-Implant Free-Flaps
Kawintip Prasongyuenyong1, Brian Kim2, Neeraj Panchal3, Brian P. Ford3, Faizan Alawi4,5
Kang I I. Ko1,6
1University of Pennsylvania School of Dental Medicine, Department of Periodontics, 2University of Pennsylvania School of Dental Medicine, 3University of Pennsylvania School of Dental Medicine, Department of Oral & Maxillofacial Surgery / Pharmacology, 4University of Pennsylvania School of Dental Medicine, Department of Basic and Translational Sciences, 5University of Pennsylvania School of Dental Medicine, Department of Academic Affairs, 6University of Pennsylvania School of Dental Medicine, Center for Clinical and Translational Research
Maladaptive Trained Immunity: A Novel Link Between Metabolic DysfunctionAssociated Steatohepatitis and Periodontal Bone Loss
Gundappa Saha1, Jonathan Korostoff2, Triantafyllos Chavakis3
George Hajishengallis1
University of Pennsylvania School of Dental Medicine, Department of Basic and Translational Sciences, 2University of Pennsylvania School of Dental Medicine, Department of Periodontics, 3Technische Universität Dresden, Institute for Clinical Chemistry and Laboratory Medicine, Faculty of Medicine
Establishment of a Biorepository Based on a Longitudinal Study of Periodontitis Progression: PerioPredict Biobank (P2B)
Evelyn Santana1, Lynn Martin1,2
Flavia R.F. Teles1,2,3
University of Pennsylvania School of Dental Medicine, Department of Basic and Translational Sciences, 2University of Pennsylvania School of Dental Medicine, Center for Innovation & Precision Dentistry, 3University of Pennsylvania School of Dental Medicine, Department of Periodontics
Longitudinal Effects of Simulated Dental Wear in Human Molars
Carinna Solano Vargas1, Diego Contreras2,3, Kristin L. Krueger4, Gavin Hale5, Lillian Befeler5
Myra F. Laird2,6
University of Pennsylvania School of Dental Medicine, 2University of Pennsylvania School of Dental Medicine, Department of Basic and Translational Sciences, 3McGill University, 4Loyola University Chicago, Department of Anthropology, 5Loyola University Chicago, 6University of Pennsylvania School of Dental Medicine, Center for Clinical and Translational Research
ECM Stress Relaxation Drives Tumor Invasion and Immune Evasion Through YAP/TAZ and TGF-β Signaling
Fathmeh Tavakoli Joorabi1,2, Amanda S. Bluem2, Dayoon Chang3, Yu-Chang J. Chen1,2
Kyle H. Vining1,3,4
1University of Pennsylvania School of Engineering and Applied Science, Department of Materials Science and Engineering, 2University of Pennsylvania School of Engineering and Applied Science, Department of Bioengineering, 3University of Pennsylvania School of Dental Medicine, Department of Preventive and Restorative Sciences, 4University of Pennsylvania School of Dental Medicine, Center for Innovation & Precision Dentistry
Precision Local Delivery of mRNA to Dental Pulp Utilizing Bisphosphonate Conjugated Ionizable Lipid
Jed Thussananutiyakul1,2,3, Jingyi Liu2,4,5, Ilchul Yoon2, Fatma Fenesha6, Gabriella Wandling6
Michael J. Mitchell4, Sarah B. Peters6, Kyle H. Vining2,5,7
1University of Pennsylvania School of Dental Medicine, Department of Orthodontics, 2University of Pennsylvania School of Dental Medicine, Department of Preventive and Restorative Sciences, 3University of Pennsylvania School of Dental Medicine, Center for Clinical and Translational Research, 4University of Pennsylvania School of Engineering and Applied Science, Department of Bioengineering, 5University of Pennsylvania School of Dental Medicine, Center for Innovation & Precision Dentistry, 6The Ohio State University, College of Dentistry, 7University of Pennsylvania School of Engineering and Applied Science, Department of Materials Science and Engineering
Inter-Individual Variability in Ibuprofen
Analgesia is Associated with Neutrophil PGE2 Production Capacity
Heba Turkstani1, Miguel A. De Leon2, Berlinda Beauvais2,3, Naser Alkandari1,4, Stacey A. Secreto2,5, John B. Lankalis2, Steven Wang2, Brian P. Ford2, Joseph A. Foote2, Neeraj Panchal2, Elliot V. Hersh2
Katherine N. Theken2
1University of Pennsylvania School of Dental Medicine, Department of Oral Medicine, 2University of Pennsylvania School of Dental Medicine, Department of Oral & Maxillofacial Surgery / Pharmacology, 3University of Pennsylvania, 4Kuwait University Faculty of Dentistry, Department of Diagnostics, 5University of Pennsylvania School of Dental Medicine, Center for Clinical and Translational Research
RD-35
Hematopoietic Stem Cell Aging as a Driver of Inflammatory Bone Loss
Xudong Wang
George Hajishengallis
University of Pennsylvania School of Dental Medicine, Department of Basic and Translational Sciences
RD-36
Nanoarchitected Platforms for Targeted Enzyme Delivery Toward Cross-Kingdom
Biofilm Inhibition
Ilchul Yoon1, Hyejoo Kim1
Geelsu Hwang1,2,3
1University of Pennsylvania School of Dental Medicine, Department of Preventive and Restorative Sciences, 2University of Pennsylvania School of Dental Medicine, Center for Innovation & Precision Dentistry, 3University of Pennsylvania School of Dental Medicine, Center for Clinical and Translational Research
RD-37
Voluntary Physical Exercise Modulates Hematopoiesis and Attenuates Periodontitis
Ying Zhou
George Hajishengallis
University of Pennsylvania School of Dental Medicine, Department of Basic and Translational Sciences
DMD STUDENT
RD-38
Viscoelasticity of Surrounding Matrix Regulates Oral Cancer Spheroid Growth
Dayoon Chang1, Fathmeh Tavakoli Joorabi2,3, Yu-Chang J. Chen2,3, Amanda S. Bluem3
Kyle H. Vining1,2,4
University of Pennsylvania School of Dental Medicine, Department of Preventive and Restorative Sciences, 2University of Pennsylvania School of Engineering and Applied Science, Department of Materials Science and Engineering, 3University of Pennsylvania School of Engineering and Applied Science, Department of Bioengineering, 4University of Pennsylvania School of Dental Medicine, Center for Innovation & Precision Dentistry
RD-39
A Small Synthetic molecule Reduces Pro-Inflammatory Cytokines in a Ligature-Induced Periodontitis Model
Aleena S. Defreitas1, Taewan Kim2, Anuradha Dhingra3
Kathleen Boesze-Battaglia3
University of Pennsylvania School of Dental Medicine, 2University of Pennsylvania School of Dental Medicine, Department of Periodontics, 3University of Pennsylvania School of Dental Medicine, Department of Basic and Translational Sciences
RD-40
Antimicrobial Therapeutic Strategies
Targeting Carcinogenic Acetaldehyde Production by Polymicrobial Oral Cocultures in Oral Squamous Cell Carcinoma
Eliana (Nhi) Diep1, Serena C. Liu2
Daniell Henry2,3
University of Pennsylvania School of Dental Medicine, 2University of Pennsylvania School of Dental Medicine, Department of Basic and Translational Sciences, 3University of Pennsylvania School of Dental Medicine, Center for Clinical and Translational Research
Acetaldehyde-Induced DNA Damage: The Oral Microbiome’s Carcinogenic Role
Yesul Kang1
Flavia R.F. Teles1,2,3, Evelyn Santana1
1University of Pennsylvania School of Dental Medicine, Department of Basic and Translational Sciences, 2University of Pennsylvania School of Dental Medicine, Department of Periodontics, 3University of Pennsylvania School of Dental Medicine, Center for Innovation & Precision Dentistry
RD-42
Compensatory E-Cadherin Remodeling Following Bacterial Challenge in the Oral Epithelium
Minyoung A. Kwon1,2, Yu Jung Heo3, Styliani Alimperti4,5
Dana T. Graves3,6,7
1University of Pennsylvania School of Dental Medicine, 2Children’s Hospital of Philadelphia, Craniofacial Orthodontics, 3University of Pennsylvania School of Dental Medicine, Department of Basic and Translational Sciences, 4University of Georgetown, Translational Medicine, 5Georgetown University, Biochemistry and Molecular & Cellular Biology Academic Department, 6University of Pennsylvania School of Dental Medicine, Department of Periodontics, 7University of Pennsylvania Perelman School of Medicine, The Penn Center for Musculoskeletal Disorders
Optimization and Standardization of Human Peripheral Blood Mononuclear Cell (PBMC)–Derived Macrophage Culture for Reproducible Inflammatory Analyses
Yin-Chu (Ingrid) Lai1, Katherine Baek1, Miguel A. De Leon2, Berlinda Beauvais2,3, Stacey A. Secreto2,4, Katherine N. Theken2
1University of Pennsylvania School of Dental Medicine, 2University of Pennsylvania School of Dental Medicine, Department of Oral & Maxillofacial Surgery / Pharmacology, 3University of Pennsylvania, 4University of Pennsylvania School of Dental Medicine, Center for Clinical and Translational Research
Targeted Delivery of STAT3-siRNA Using a Mineralized Tissue-Targeting Expression System (MiTEX) for Periodontal Disease Therapy
Yuantong (Rachel) Li1, Jingyi Liu1,2,3, Doris Chen1,4, Hardikk Makkar1,3, Yu-Chang J. Chen2,5, Jed Thussananutiyakul1,6,7, Shuchen Zhang1
Kyle H. Vining1,2,3,5
University of Pennsylvania School of Dental Medicine, Department of Preventive and Restorative Sciences, 2University of Pennsylvania School of Engineering and Applied Science, Department of Bioengineering, 3University of Pennsylvania School of Dental Medicine, Center for Innovation & Precision Dentistry, 4University of Pennsylvania School of Dental Medicine, Department of Periodontics, 5University of Pennsylvania School of Engineering and Applied Science, Department of Materials Science and Engineering, 6University of Pennsylvania School of Dental Medicine, Department of Orthodontics, 7University of Pennsylvania School of Dental Medicine, Center for Clinical and Translational Research
RD-45
Antimicrobial Peptide Suppression of Carcinogenic Acetaldehyde Production in OSCC Patients
Serena C. Liu1, Geetanjali Wakade2
Daniell Henry1,2
University of Pennsylvania School of Dental Medicine, Department of Basic and Translational Sciences, 2University of Pennsylvania School of Dental Medicine, Center for Clinical and Translational Research
RD-46
Panoramic Radiographs for Bone Fragility Screening in PWH
Stephanie Moga1, Kevin Fan1, Praise Okoh-Aihe1, Adeyinka Dayo2, Mel Mupparapu2
Temitope T. Omolehinwa1,2
University of Pennsylvania School of Dental Medicine, Center for Clinical and Translational Research, 2University of Pennsylvania School of Dental Medicine, Department of Oral Medicine
Progressive Partially Methylated Domain
Erosion and Targeted ZNF471 Silencing
Define Two Independent Epigenetic Programs in Oral Premalignancy
Michael E. Troka1
James C. Gates2
University of Pennsylvania School of Dental Medicine, 2University of Pennsylvania School of Dental Medicine, Department of Oral & Maxillofacial Surgery / Pharmacology
Exploring Sex-Dimorphism in Periodontitis
Severity and Progression
Amy M. Wong1, Michael J. Kallan2
Flavia R.F. Teles3,4,5
University of Pennsylvania School of Dental Medicine, 2University of Pennsylvania Perelman School of Medicine, Center for Clinical Epidemiology and Biostatistics, 3University of Pennsylvania School of Dental Medicine, Department of Basic and Translational Sciences, 4University of Pennsylvania School of Dental Medicine, Department of Periodontics, 5University of Pennsylvania School of Dental Medicine, Center for Innovation & Precision Dentistry
Spatial Distribution of Streptococcus mutans and Candida albicans Biofilms on 3D-Printed Molar Models
Sachet Amin1
Pratik Nag2, Geelsu Hwang2,3,4
1University of Pennsylvania School of Dental Medicine, 2University of Pennsylvania School of Dental Medicine, Department of Preventive and Restorative Sciences, 3University of Pennsylvania School of Dental Medicine, Center for Innovation & Precision Dentistry, 4University of Pennsylvania School of Dental Medicine, Center for Clinical and Translational Research
Quercetin Inhibits MRGPRX2-Mediated Mast Cell Activation; Implication for Periodontal Disease
Bahar Azadi1,2
1University of Pennsylvania School of Dental Medicine, Center for Innovation & Precision Dentistry, 2University of Pennsylvania School of Dental Medicine, Department of Basic and Translational Sciences
Transforming Dental Restorations with Embedded BTO-AU Nanoparticles
Victoria Chan1, Ilchul Yoon2, Pratik Nag2
Geelsu Hwang2,3,4
1University of Pennsylvania School of Dental Medicine, 2University of Pennsylvania School of Dental Medicine, Department of Preventive and Restorative Sciences, 3University of Pennsylvania School of Dental Medicine, Center for Innovation & Precision Dentistry, 4University of Pennsylvania School of Dental Medicine, Center for Clinical and Translational Research
Topical Delivery of mRNA Therapeutics to Dentin Using Lipid Nanoparticles
Jimmy Cheng1, Jed Thussananutiyakul2,3,4, Ilchul Yoon3, Michael J. Mitchell5
Kyle H. Vining3,6,7
University of Pennsylvania School of Dental Medicine, 2University of Pennsylvania School of Dental Medicine, Department of Orthodontics, 3University of Pennsylvania School of Dental Medicine, Department of Preventive and Restorative Sciences, 4University of Pennsylvania School of Dental Medicine, Center for Clinical and Translational Research, 5University of Pennsylvania School of Engineering and Applied Science, Department of Bioengineering, 6University of Pennsylvania School of Dental Medicine, Center for Innovation & Precision Dentistry, 7University of Pennsylvania School of Engineering and Applied Science, Department of Materials Science and Engineering
RD-53
The Role of YAP/TAZ in Bone Marrow Mesenchymal Stem Cells
Kaining (Kenny) Feng1
Chider Chen2
University of Pennsylvania School of Dental Medicine, 2University of Pennsylvania School of Dental Medicine, Department of Oral & Maxillofacial Surgery / Pharmacology
RD-54
Effect of Osteoarthritis on Peri-Implantitis
Edwin Lee
University of Pennsylvania School of Dental Medicine
RD-55
Application of Shikonin for Targeted Inhibition of OSCC Cell Viability and Related Tumor-Associated Macrophages
Zicong Li1
Qunzhou Zhang2, Ahn D. Le2
University of Pennsylvania School of Dental Medicine, 2University of Pennsylvania School of Dental Medicine, Department of Oral & Maxillofacial Surgery / Pharmacology
RD-56
Reprogramming M2-like Tumor Associated Macrophages by TLR7/8 Agonists Towards M1-like Phenotypes in Oral Cancer
Christina Li
Qunzhou Zhang, Anh Le, Shihong Shi
University of Pennsylvania School of Dental Medicine, Department of Oral & Maxillofacial Surgery / Pharmacology
RD-57
Ferroptosis Drives Pro-Inflammatory Macrophage and Neutrophil Activation in Experimental Periodontitis and is Suppressed by UAMC-3203
Annabella Li1, William S. Kim2, Yeriel Yoon2
Kang I. Ko2
University of Pennsylvania School of Dental Medicine, 2University of Pennsylvania School of Dental Medicine, Department of Periodontics
RD-58
Antibiofilm Impact of Barium Titanate-Gold Nanoparticle Coating on Tooth Surfaces
Emily Luo1
Geelsu Hwang2,3,4
University of Pennsylvania School of Dental Medicine, 2University of Pennsylvania School of Dental Medicine, Department of Preventive and Restorative Sciences, 3University of Pennsylvania School of Dental Medicine, Center for Innovation & Precision Dentistry, 4University of Pennsylvania School of Dental Medicine, Center for Clinical and Translational Research
RD-59
Braces vs Clear Aligners: A Comparative Study on Surgical Morbidity in Orthognathic Surgery
Amanda Mavricos1, John Button1,2, Gina Chryssofos3
Brian P. Ford1,4,5
1University of Pennsylvania School of Dental Medicine, Department of Oral & Maxillofacial Surgery / Pharmacology, 2University of Pennsylvania School of Dental Medicine, Center for Integrative Global Oral Health, 3University of Pennsylvania School of Dental Medicine, 4Philadelphia VA Medical Center, 5Children’s Hospital of Philadelphia, Division of Plastic and Reconstructive Surgery
RD-60
MRGPRX2-Dependent Mast Cell Activation by Antimicrobial Polymers for Oral Immunity
Harsha Meduru
University of Pennsylvania School of Dental Medicine
RD-61
Natural Flavonoid Fisetin Mitigates Cellular Senescence in Gingival Epithelial Cells
Jeslyn Mei1, Jenna M. Fattore2, Samuel F. Suslavich3, Megi G. Hysa3,4,5, Xia-Juan Xia3, S Esra S. Sahingur3
1University of Pennsylvania School of Dental Medicine, 2University of Tampa, 3University of Pennsylvania School of Dental Medicine, Department of Periodontics, 4University of Pennsylvania School of Arts and Sciences, Department of Biology, 5University of Pennsylvania
RD-62
Effect of Immediate Implant Bone Augmentation of Post-Op Inflammatory Conditions
Sean Moran
University of Pennsylvania School of Dental Medicine
RD-63
Bite to Bolus: Understanding Food Particle Breakdown and Chewing Efficiency
Artie P. Nayak1, Amy M. Wong1, Stephanie L. Canington2, Taylor Rutigliano1, Geelsu Hwang2,3,4
Myra F. Laird2,5
University of Pennsylvania School of Dental Medicine, 2University of Pennsylvania School of Dental Medicine, Center for Clinical and Translational Research, 3University of Pennsylvania School of Dental Medicine, Department of Preventive and Restorative Sciences, 4University of Pennsylvania School of Dental Medicine, Center for Innovation & Precision Dentistry, 5University of Pennsylvania School of Dental Medicine, Department of Basic and Translational Sciences
RD-64
TSC’s Proliferative and Differentiation Properties for Tissue Regeneration
Gina J. Oh1
Chider Chen2
University of Pennsylvania School of Dental Medicine, 2University of Pennsylvania School of Dental Medicine, Department of Oral & Maxillofacial Surgery / Pharmacology
RD-65
Topography-Dependent Cross-Kingdom Biofilm Formation on Hydroxyapatite
Tooth Models
Rachel Park
University of Pennsylvania School of Dental Medicine
RD-66
Condylar Changes in Temporomandibular Joint Development in Mice Animal Models
Renali Patel1, Shilan Zhang2
Wenjing Yu3
University of Pennsylvania School of Dental Medicine, 2University of Pennsylvania School of Dental Medicine, Department of Basic and Translational Sciences, 3University of Pennsylvania School of Dental Medicine, Department of Orthodontics
RD-67
Microplastic Exposure as an Emerging Risk Factor for Cardiovascular Disease and Diabetes Mellitus
Parth Patel1
Hyeran Jeon2
University of Pennsylvania School of Dental Medicine, 2University of Pennsylvania School of Dental Medicine, Department of Orthodontics
RD-68
Utilization of Enzyme-Loaded Nanocarriers to Disrupt Oral Biofilms
Dhruvi Patel1
Geelsu Hwang2,3,4
University of Pennsylvania School of Dental Medicine, 2University of Pennsylvania School of Dental Medicine, Department of Preventive and Restorative Sciences, 3University of Pennsylvania School of Dental Medicine, Center for Innovation & Precision Dentistry, 4University of Pennsylvania School of Dental Medicine, Center for Clinical and Translational Research
RD-69
Flexural Strength of Compositional Gradient Multilayer Zirconia under High-Speed Sintering
Connor Riesenberger1, Longfei He2,3,4
Yu Zhang2,5
University of Pennsylvania School of Dental Medicine, 2University of Pennsylvania School of Dental Medicine, Department of Preventive and Restorative Sciences, 3Stomatological Hospital of Weifang People’s Hospital, Department of Pediatric Dentistry, 4Children’s Hospital of Philadelphia, Craniofacial Orthodontics, 5University of Pennsylvania School of Dental Medicine, Department of Basic and Translational Sciences
Preoperative Psychological Predictors of Outpatient Pain Trajectory Post-ThirdMolar Extraction
Natalie H. Wang1, Emily F. Shekhtman1, Steven Wang2,3, Stacey A. Secreto3,4, Rania A. Habib3, Brian P. Ford3,5,6, Neeraj Panchal3, Elliot V. Hersh3
Katherine N. Theken3
1University of Pennsylvania School of Dental Medicine, 2University of Pennsylvania Perelman School of Medicine, Department of Oral and Maxillofacial Surgery, 3University of Pennsylvania School of Dental Medicine, Department of Oral & Maxillofacial Surgery / Pharmacology, 4University of Pennsylvania School of Dental Medicine, Center for Clinical and Translational Research, 5Philadelphia VA Medical Center, 6Children’s Hospital of Philadelphia, Division of Plastic and Reconstructive Surgery
Mesenchymal Stem Cell Behaviors during Rapid Maxillary Expansion
Lia Wilmoth1
Wenjing Yu2
1University of Pennsylvania School of Dental Medicine, 2University of Pennsylvania School of Dental Medicine, Department of Orthodontics
Osteoblast-specific FoxO1 Deficiency Mitigates T2DM-Induced Bone Loss
You (Grace) Wu1, Yang Yang2, Longyu Li2, Abdulaziz Hakeem2,3,4, Shuting Yang2
Dana T. Graves2,5,6, Shuying Yang2
1University of Pennsylvania School of Dental Medicine, 2University of Pennsylvania School of Dental Medicine, Department of Basic and Translational Sciences, 3Umm Al Qura University School of Dentistry, Department of Basic and Translation Science, 4University of Pennsylvania Perelman School of Medicine, Department of Orthopaedic Surgery, 5University of Pennsylvania School of Dental Medicine, Department of Periodontics, 6University of Pennsylvania Perelman School of Medicine, The Penn Center for Musculoskeletal Disorders
Investigating the Impact of MechanoEducated Dendritic Cells on OSCC Response to Anti-PD1 Therapy
Shuchen Zhang1, Amanda S. Bluem2, Fathmeh Tavakoli Joorabi2,3, Kexin Zhang3
Yu-Chang J. Chen2,3, Kyle H. Vining1,2,3,4
University of Pennsylvania School of Dental Medicine, Department of Preventive and Restorative Sciences, 2University of Pennsylvania School of Engineering and Applied Science, Department of Bioengineering, 3University of Pennsylvania School of Engineering and Applied Science, Department of Materials Science and Engineering, 4University of Pennsylvania School of Dental Medicine, Center for Innovation & Precision Dentistry
DMD STUDENT
RD-74
Association Between Obstructive Sleep Apnea and Postoperative Opioid Utilization After Orthognathic Surgery: A Retrospective Cohort Study
Ryan A. Alt1, John Button2, Amanda Mavricos1
Brian P. Ford1,3,4
University of Pennsylvania School of Dental Medicine, Department of Oral & Maxillofacial Surgery / Pharmacology, 2University of Pennsylvania School of Dental Medicine, Center for Integrative Global Oral Health, 3Philadelphia VA Medical Center, 4Children’s Hospital of Philadelphia, Division of Plastic and Reconstructive Surgery
RD-75
Effect of Polishing Methods on Surface Roughness and Gloss of Additive Manufactured Restorative Materials
Helen Alvis1, Tariq Alsahafi2
Taiseer Sulaiman2
University of Pennsylvania School of Dental Medicine, 2University of North Carolina at Chapel Hill, Adams School of Dentistry, Department of Restorative Sciences
RD-76
Identifying Meaningful Potentially Modifiable Metabolic Abnormalities in Oral Cancer Patients
Gabriella N. Casiano, Dylan M. Crann
James C. Gates
University of Pennsylvania School of Dental Medicine, Department of Oral & Maxillofacial Surgery / Pharmacology
RD-77
Full Pulpotomy Versus Root Canal Treatment in Mature Permanent Teeth with Symptomatic Irreversible Pulpitis: A Systematic Review and Meta-Analysis
Seowon Chang
University of Pennsylvania School of Dental Medicine
Individual Patient Solutions (IPS) Implants® Preprosthetic for Complex Dental Rehabilitation: An Alternative Treatment Modality
Dylan M. Crann1
Brian P. Ford1,2,3
1University of Pennsylvania School of Dental Medicine, Department of Oral & Maxillofacial Surgery / Pharmacology, 2Philadelphia VA Medical Center, 3Children’s Hospital of Philadelphia, Division of Plastic and Reconstructive Surgery
RD-79
Quantifying Epigenetic Aging Acceleration Among Individuals with and without HIV
Sonia Dalal1, Anil Kumar2, Peter Kavecky2, Yijing Su3, Temitope T. Omolehinwa2,3, Modupe O. Coker2,3,4
1University of Pennsylvania School of Dental Medicine, 2University of Pennsylvania School of Dental Medicine, Center for Clinical and Translational Research, 3University of Pennsylvania School of Dental Medicine, Department of Oral Medicine, 4University of Pennsylvania School of Dental Medicine, Department of Basic and Translational Sciences
Microbial Community Patterns in Medication-Related Osteonecrosis of the Jaw: A Culture-Based Analysis
Taylor M. DeVine1, Ryan Elder1, Srighana Nadella2
Katherine N. Theken2, Neeraj Panchal2, Puhan He2
1University of Pennsylvania School of Dental Medicine, 2University of Pennsylvania School of Dental Medicine, Department of Oral & Maxillofacial Surgery / Pharmacology
RD-81
Relationship Between Adipokines and Opioid Use Following Third Molar Extraction
Nicole M. Farkouh1, Camille Jordan1,2, Stacey A. Secreto3,4, Steven Wang4,5, Rania A. Habib4, Brian P. Ford4, Neeraj Panchal4, Elliot V. Hersh4
Katherine N. Theken4
University of Pennsylvania School of Dental Medicine, 2University of Pennsylvania School of Arts and Sciences, Department of Biology, 3University of Pennsylvania School of Dental Medicine, Center for Clinical and Translational Research, 4University of Pennsylvania School of Dental Medicine, Department of Oral & Maxillofacial Surgery / Pharmacology, 5University of Pennsylvania Perelman School of Medicine, Department of Oral and Maxillofacial Surgery
RD-82
MOLAR Audit Study: Evaluating Access to Dental Care Across Public and Private Insurance
Sonia Gazula, Alyssia Liu, Heather Loo University of Pennsylvania School of Dental Medicine
RD-83
Variation in Fiber Type Phenotypes Across Development in the Chewing Muscles of Sapajus
Julia M. Gerstman1, Myra F. Laird2,3, Megan A. Holmes4
University of Pennsylvania School of Dental Medicine, 2University of Pennsylvania School of Dental Medicine, Center for Clinical and Translational Research, 3University of Pennsylvania School of Dental Medicine, Department of Basic and Translational Sciences, 4Duke University School of Medicine, Department of Family Medicine and Community Health
RD-84
Grinding Out the Details: How Wear Reshapes Tooth Morphology
Shahd L. Habeb1, Diego Contreras1,2, Tucker Sprayberry1, Stephanie L. Canington1, Kristin L. Krueger3
Myra F. Laird1,4
University of Pennsylvania School of Dental Medicine, Department of Basic and Translational Sciences, 2McGill University, 3Loyola University Chicago, Department of Anthropology, 4University of Pennsylvania School of Dental Medicine, Center for Clinical and Translational Research
RD-85
A Holistic Analysis of the Association Between Temporomandibular Disorders, Obstructive Sleep Apnea, and Psychosocial Conditions: A Review of Literature
Farraz Haider1, Issa Elabed2, Allison Lo2, Taylor M. DeVine2, Anna-Maria Haddad2, Rubba Al-Kafaji2, Mohammad Asfour2, Mutasem Al Jariri2, Hadi Bouali3
Stefania Brazzoli1
University of Pennsylvania School of Dental Medicine, Department of Oral Medicine, 2University of Pennsylvania School of Dental Medicine, 3University of Pennsylvania School of Dental Medicine, Department of Oral & Maxillofacial Surgery / Pharmacology
RD-86
Preoperative Orthodontic Measures of Overjet and Overbite as Predictors of Anesthesia Time, Operative Time, and Complications in Orthognathic Surgery
Matthew Halpert1,2, Jasmine Shokri1,2, John Button2,3, Amanda Mavricos2
Brian P. Ford2,4,5
University of Pennsylvania School of Dental Medicine, Department of Oral Medicine, 2University of Pennsylvania School of Dental Medicine, Department of Oral & Maxillofacial Surgery / Pharmacology, 3University of Pennsylvania School of Dental Medicine, Center for Integrative Global Oral Health, 4Philadelphia VA Medical Center, 5Children’s Hospital of Philadelphia, Division of Plastic and Reconstructive Surgery
Detection and Control of Hydrogen Sulfide Produced by Oral CancerAssociated Bacteria
Korrie Han1, Serena C. Liu1
Daniell Henry1,2
1University of Pennsylvania School of Dental Medicine, Department of Basic and Translational Sciences, 2University of Pennsylvania School of Dental Medicine, Center for Clinical and Translational Research
Impacts of Intimate Partner Violence on Head and Neck Health and Survivors’ Healthcare Experiences
Lauren A. Hogstrom1, Carolina Guillen1, Lilian Arce1, Maggie Junkin2
Katherine A. France3,4
1University of Pennsylvania School of Dental Medicine, 2Maurice H. Kornberg School of Dentistry at Temple University, 3University of Pennsylvania School of Dental Medicine, Department of Oral Medicine, 4University of Pennsylvania School of Dental Medicine, Care Center for Persons with Disabilities
Targeting the STAT3 Signaling Pathway to Modulate Inflammation and Enhance Regenerative Potential in Dental Pulp Stem Cells
Seoyun Jang1, Shuchen Zhang2, BingLing Chen1,3,4
Kyle H. Vining2,5,6
1University of Pennsylvania School of Dental Medicine, 2University of Pennsylvania School of Dental Medicine, Department of Preventive and Restorative Sciences, 3University of Pennsylvania School of Arts and Sciences, Department of Biology, 4Children’s Hospital of Philadelphia, Craniofacial Orthodontics, 5University of Pennsylvania School of Dental Medicine, Center for Innovation & Precision Dentistry, 6University of Pennsylvania School of Engineering and Applied Science, Department of Materials Science and Engineering
RD-90
GIMAP6 is a Novel Regulator of Osteoblast-Mediated Bone Formation
John Kim1, Abdulaziz Hakeem1,2,3, Tarun Sama1, Shuting Yang1, Ken Chen1
Shuying Yang1
1University of Pennsylvania School of Dental Medicine, Department of Basic and Translational Sciences, 2Umm Al Qura University School of Dentistry, Department of Basic and Translation Science, 3University of Pennsylvania Perelman School of Medicine, Department of Orthopaedic Surgery
RD-91
From Accommodation to Standard of Care: Sensory-Adapted Dentistry to Improve Treatment Tolerance in Neurodiverse Young Adults with Autism Spectrum Disorder
Kimberlyn Ledesma, Anngella Orraiz Orraiz
University of Pennsylvania School of Dental Medicine
RD-92
Therapeutic Potential of Optimized GMSC-derived Secretomes on Temporomandibular Joint Osteoarthritis
Annabel S. Liao1, Uddhab Karki2, Shihong Shi2, Qunzhou Zhang2
Ahn D. Le2
University of Pennsylvania School of Dental Medicine, 2University of Pennsylvania School of Dental Medicine, Department of Oral & Maxillofacial Surgery / Pharmacology
RD-93
Evaluation of CYP2C9 Polymorphisms as Predictors of NSAID Response After Third Molar Extractions
Sydney Liu1
Katherine N. Theken2
University of Pennsylvania School of Dental Medicine, 2University of Pennsylvania School of Dental Medicine, Department of Oral & Maxillofacial Surgery / Pharmacology
RD-94
Bonding Performance of a Universal Adhesive Resin Cementation System on Zirconia, Lithium Disilicate Glass-Ceramic, Enamel, and Dentin Surfaces
Allison Liu1, Asha Sunkara1, Adam Kadan1
Fusun Ozer1, Markus B. Blatz1,2
University of Pennsylvania School of Dental Medicine, Department of Preventive and Restorative Sciences, 2University of Pennsylvania School of Dental Medicine, Center for Innovation & Precision Dentistry
RD-95
Factors Influencing Access to Dental Care and Maintenance of Oral Health
Dylan N. Ohayon1, Joonhyeog Park2, Jaelyn Liu2, Xinyue Li2, Jinbo Niu2,3
Katherine A. France3,4, Tamara J. Cadet2,3
University of Pennsylvania School of Dental Medicine, 2University of Pennsylvania School of Social Policy and Practice, 3University of Pennsylvania School of Dental Medicine, Department of Oral Medicine, 4University of Pennsylvania School of Dental Medicine, Care Center for Persons with Disabilities
RD-96
Direct vs. Indirect Veneers on Demineralized Enamel: Material Selection, Adhesive Predictability, and Ethical Boundaries After Orthodontic Treatment. A Clinical Case
Anngella Orraiz Orraiz
University of Pennsylvania School of Dental Medicine
RD-97
Clinical Performance of Two Fluoride Releasing Resin Materials in Class I Posterior Restorations After 12 Years
Brittnie Pang1, Markus B. Blatz2,3, Oksana Yakymiv1 Fusun Ozer2
University of Pennsylvania School of Dental Medicine, 2University of Pennsylvania School of Dental Medicine, Department of Preventive and Restorative Sciences, 3University of Pennsylvania School of Dental Medicine, Center for Innovation & Precision Dentistry
The Interplay Between Neutrophils and Mid-Palatal Suture Mesenchymal Stem Cells (MSCs)
Ghazaal Parastooei1,2
Wenjing Yu3
1University of Pennsylvania School of Dental Medicine, 2University of Maryland School of Dentistry, Department of Neural and Pain Sciences, 3University of Pennsylvania School of Dental Medicine, Department of Orthodontics
Cell Origins and Key Molecular Regulators of the Craniobase Skeletal Development
Christy Qian1
Chenshuang Li2, Chider Chen3
1University of Pennsylvania School of Dental Medicine, 2University of Pennsylvania School of Dental Medicine, Department of Orthodontics, 3University of Pennsylvania School of Dental Medicine, Department of Oral & Maxillofacial Surgery / Pharmacology
Population-Level Harms of Systemic Oral Antibiotic use in the U.S. Dental Care Settings: Preliminary Findings of a Systematic Review
Andrian Radaios1, Matthias Wallach Weinstein, DDS2, Carla Massignan, DDS, MSc, PhD3
Francisca Verdugo-Paiva, DDS, MSc4, Alonso Carrasco-Labra, DDS, MSc, PhD4
1University of Pennsylvania School of Dental Medicine, 2Universidad del Desarrollo, Santiago, Chile, Departamento de Morfología, Facultad de Medicina, 3University of Illinois Chicago College of Dentistry, Chicago, IL, Clinical Associate Professor, Department of Pediatric Dentistry, 4University of Pennsylvania School of Dental Medicine, Center for Integrative Global Oral Health
Variability in Occlusal Force Distribution During Instructed Biting Tasks
Taylor Rutigliano1, Artie P. Nayak1, Amy M. Wong1, Stephanie L. Canington2, Geelsu Hwang3,4,5
Myra F. Laird2,5
University of Pennsylvania School of Dental Medicine, 2University of Pennsylvania School of Dental Medicine, Department of Basic and Translational Sciences, 3University of Pennsylvania School of Dental Medicine, Department of Preventive and Restorative Sciences, 4University of Pennsylvania School of Dental Medicine, Center for Innovation & Precision Dentistry, 5University of Pennsylvania School of Dental Medicine, Center for Clinical and Translational Research
Comparative Effects of Conventional and High-Speed Sintering on the Translucency of Compositional Gradient Multilayer Zirconia
Spencer J. Sattazahn1,2, Longfei He1,3,4
Yu Zhang1,5
University of Pennsylvania School of Dental Medicine, Department of Preventive and Restorative Sciences, 2Children’s Hospital of Philadelphia, Division of Plastic and Reconstructive Surgery, 3Stomatological Hospital of Weifang People’s Hospital, Department of Pediatric Dentistry, 4Children’s Hospital of Philadelphia, Craniofacial Orthodontics, 5University of Pennsylvania School of Dental Medicine, Department of Basic and Translational Sciences
The Influence of Framework Material on Fit Accuracy of Complete Arch Implant Supported Prostheses Fabricated with Different Digital Impression Techniques
Emma S. Savitsky1, Sebastian Ollinger2
Markus B. Blatz2,3
University of Pennsylvania School of Dental Medicine, 2University of Pennsylvania School of Dental Medicine, Department of Preventive and Restorative Sciences, 3University of Pennsylvania School of Dental Medicine, Center for Innovation & Precision Dentistry
Gene-Specific Dental and Oral Manifestations of Epidermolysis Bullosa
Natalie Shah1,2, David Shon3, Marissa Perman4, Hannah Mumber4, Elizabeth Bhoj5
Kei Katsura1,6
Children’s Hospital of Philadelphia, Department of Pediatrics, 2University of Pennsylvania School of Dental Medicine, Department of Clinical Pediatric Dentistry, 3University of Pennsylvania School of Arts and Sciences, Department of Biology, 4University of Pennsylvania Perelman School of Medicine, Department of Dermatology, 5Children’s Hospital of Philadelphia, Division of Human Genetics, 6University of California, San Francisco
RD-105
Preoperative Airway Assessment in Orthognathic Surgery: Implications for Orthodontics
Jasmine Shokri1,2, Matthew Halpert1,2, John Button2,3, Amanda Mavricos2
Brian P. Ford2,4,5
University of Pennsylvania School of Dental Medicine, Department of Oral Medicine, 2University of Pennsylvania School of Dental Medicine, Department of Oral & Maxillofacial Surgery / Pharmacology, 3University of Pennsylvania School of Dental Medicine, Center for Integrative Global Oral Health, 4Philadelphia VA Medical Center, 5Children’s Hospital of Philadelphia, Division of Plastic and Reconstructive Surgery
RD-106
Matrix Stiffness Regulates the Morphology of Dental Pulp Stem Cells and their Immunomodulatory Functions
Heewon (Karen) Sohn1, Myung Jin (Jina) Lee1, Yu-Chang J. Chen2,3
Kyle H. Vining1,2,4
University of Pennsylvania School of Dental Medicine, Department of Preventive and Restorative Sciences, 2University of Pennsylvania School of Engineering and Applied Science, Department of Materials Science and Engineering, 3University of Pennsylvania School of Engineering and Applied Science, Department of Bioengineering, 4University of Pennsylvania School of Dental Medicine, Center for Innovation & Precision Dentistry
Fisetin Targets Senescence Pathways to Suppress Periodontal Inflammaging
Samuel F. Suslavich1, Jenna M. Fattore2, Xia-Juan Xia1, S M Ziauddin3, Megi G. Hysa1,4,5
S Esra S. Sahingur1
1University of Pennsylvania School of Dental Medicine, Department of Periodontics, 2University of Tampa, 3Adams School of Dentistry, University of North Carolina at Chapel Hill, Department of Periodontology, Endodontics, and Dental Hygiene, 4University of Pennsylvania School of Arts and Sciences, Department of Biology, 5University of Pennsylvania
A Digital Twin of the Extraction Socket: Predicting Patient-Specific Alveolar Ridge Resorption
William C. Tsai1, Akshaya N. Bhati2,3, Dayoon Chang4
Yu-Cheng Chang5, Rahul Mangharam2
1University of Pennsylvania School of Dental Medicine, 2University of Pennsylvania School of Engineering and Applied Science, Department of Electrical and Systems Engineering, 3University of Pennsylvania School of Veterinary Medicine, 4University of Pennsylvania School of Dental Medicine, Department of Preventive and Restorative Sciences, 5University of Pennsylvania School of Dental Medicine, Department of Periodontics
Association between PTGS1 Polymorphisms and Opioid Use After Third Molar Extraction
Marvin Min Tun
Katherine N. Theken
University of Pennsylvania School of Dental Medicine, Department of Oral & Maxillofacial Surgery / Pharmacology
Modeling Pulpitis Inflammation via TNF-α Activation of Peripheral Blood Monocytes
Suyoung Yun1, Kexin Zhang2, Yuchen Jiang1,2, Kyle H. Vining2,3,4,5
University of Pennsylvania School of Dental Medicine, 2University of Pennsylvania School of Engineering and Applied Science, Department of Materials Science and Engineering, 3University of Pennsylvania School of Engineering and Applied Science, Department of Bioengineering, 4University of Pennsylvania School of Dental Medicine, Department of Preventive and Restorative Sciences, 5University of Pennsylvania School of Dental Medicine, Center for Innovation & Precision Dentistry


The Fund for Oral Health was established to provide critical support for research pilot funding, bridge funding for labs, facility and equipment enhancements, and other scholarly activities. Scan to donate today.